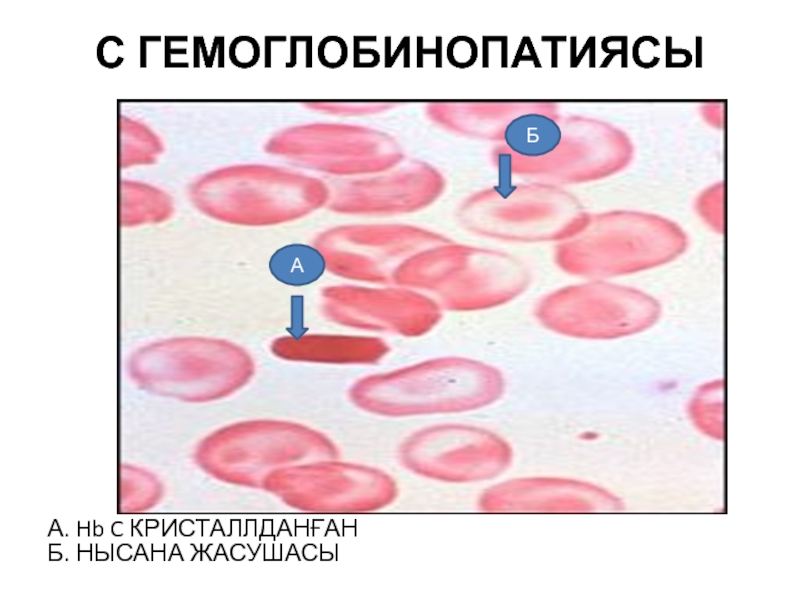

Разделы презентаций
- Разное
- Английский язык
- Астрономия
- Алгебра
- Биология
- География
- Геометрия
- Детские презентации
- Информатика
- История
- Литература
- Математика
- Медицина
- Менеджмент
- Музыка
- МХК
- Немецкий язык
- ОБЖ
- Обществознание
- Окружающий мир
- Педагогика
- Русский язык
- Технология
- Физика
- Философия
- Химия
- Шаблоны, картинки для презентаций
- Экология
- Экономика
- Юриспруденция
Бактериальді менингит
Содержание
- 1. Бактериальді менингит
- 2. Бактериальді менингитА. Мидың жұмсақ қабаты Б.Торлы қабаты
- 3. Туберкулезді менингитА.Ми бағаны Б.Экссудат В.Самай бөлігі АББВВ
- 4. Туберкулезді менингоэнцефалитА. базальді ганглилердің Некрозы Б. Ми қабаттарының Фиброз ААББ
- 5. Туберкулезді менингоэнцефалит А.Ми қыртысы Б.Менингеальді қабық В.Ми тініне қабынудын таралуы Г.Менингеальді қантамыр некроздалған қабатпен АБВГ
- 6. Вирусты энцефалит (herpes simplex) А. көру қиылысы Б.Некроз В.Медиальді самай бөлігі Г. Төменгі самай бөлігіВГББА
- 7. Вирусты менингоэнцефалит (herpes simplex)А.Периваскулярлы лимфоцитарлы инфильтрат Б.Микроглиальді түйін некрозбен АБ
- 8. нағыз ПОЛИЦИТЕМИЯ А.Мегакариоциттер Б.Толыспаған эритроидті жасушалар ААББ
- 9. ЭССЕНЦИАЛЬДІ ТРОМБОЦИТЕМИЯА. МегакарициттерАА
- 10. Асқазан лимфомасы А. Асқазан бездері Б.Лимфоэпителиалді бүлінісВ. Меншікті пластинкада лимфоцитарлы инфильтрат ВБА
- 11. 1- Ходжкин лимфомасыА. Рид – Штеринберг жасушасыБ. Кіші лимфоциттеріВ.Плазматикалық жасушаВАБ
- 12. 2. Ходжкин лимфомасыА. Рид – Штеринберг жасушасыБ. Кіші лимфоциттеріВ. ЭозинофилдерВБА
- 13. 3. Ходжкин лимфомасы (аралас – жасушалы
- 14. 4. Ходжкин лимфомасыА. Лимфоидты түйінБ. Склероз БА
- 15. 5. Ходжкин – Лимфомасы (нодулярлы склероз)А. Лакунарлы жасушаларБ. Кіші лимфоцит ААБ
- 16. 6. Ходжкин лимфомасы (лимфоциттері басымырақ) А. Попкорн (L§H) жасушаларыБ. Кіші лимфоциттеріААБ
- 17. 7. Фоликулярлы лимфома А. Кіші лимфоциттер бөлшектелген ядроменБ. Үлкен лимфоциттер бүтін ядромен АББА
- 18. Беркитт Лимфомасы А.жасушаның макрофакпен жұтылуы Б.митоз кесінділері АБА
- 19. Жіңішке ішек . БЕРКИТТ ЛИМФОМАСЫ А.ісіктің серозды қабықтан шығып тұруы Б.жіңішке ішектің шырышты қабығыАБ
- 20. жіті ПРОМИЕЛОЦИТАРлы ЛЕЙКОЗ кезіндегі ҚЫЗЫЛ СҮЙЕК КЕМІГІ А.ҚЫЗЫЛ СҮЙЕК КЕМІГІНІҢ гипержасушасы Б.сүйектік трабекулалар АБ
- 21. МАЛЯРИЯ кезіндегі ГЕМОЛИТИКАЛЫҚ АНЕМИЯ А. ПЛАЗМОДИЯНЫҢ сақиналы ФОРМАСЫ А
- 22. Тұқымқуалаушылық СФЕРОЦИТОЗ А. ПОЛИХРОМАТОФИЛЬДІ ҚЫЗЫЛ ЖАСУШАСЫ Б.СФЕРОЦИТ В. Қалыпты ЭРИТРОЦИТАВБ
- 23. ß-ТАЛАССЕМИЯ А. құрамында ядросы бар ЭРИТРОЦИТ, Б.НЫСАНА жасушасы ББА
- 24. ҚЫЗЫЛ СҮЙЕК КЕМІГІНІҢ ГЕМОЛИЗГЕ ЖАУАБЫА. ЭРИТРОЦИТТЕР ІЗДЕРІАА
- 25. С ГЕМОГЛОБИНОПАТИЯСЫА. Hb C КРИСТАЛЛДАНҒАН Б. НЫСАНА ЖАСУШАСЫ АБ
- 26. Криптококкты менингит А.БАС МИ ТІНІ Б.ТАМЫРЛАР В.МЕНИНГЕАЛЬДІ АЙМАҚ С.КРИПТОКОККТАР АБВГ
- 27. Бас ми абсцессіА.ГРАНУЛЯЦИЯЛЫҚ ТІНБ. ШАШЫРАҢҚЫ НЕЙТРОФИЛДЕР ЖӘНЕ НЕКРОТИКАЛЫҚ МАССАЛАР БА
- 28. ҚАПТАЛҒАН АНЕВРИЗМА.ОҢ ЖАҚ ОМЫРТҚАЛЫҚ АРТЕРИЯ Б.САМАЙ ҮЛЕСІ В.АНЕВРИЗМА Г.ХИРУРГИЯЛЫҚ КЛИПСАЛАР ВБАГ
- 29. Артериовеноздық мальформацияА.МАЛЬФОРМАЦИОНДЫ АЙМАҚ А
- 30. А. ишемиялық инфарктісінің аймағы ИШЕМИЯЛЫҚ ИНФАРКТА
- 31. Көпір аймағындағы бас ми инфарктісіА.көпіршік Б.инфаркт аймағы В.базилярдың артериясының тромбозы Г.Мишық БАВГ
- 32. Бас миының ортаңғы ми артериясының бассейіндегі инфаркты А. жаңа инфаркт аймағы А
- 33. Организациялық ИнфарктА.Организациялық инфаркт аймағы А
- 34. Бас миының геморагиялық инфарктісі А.ГЕМОРРАГИЯЛЫҚ ИНФАРКТБ.ГИПППОКАМПВ.қара зат Г.аяқшалар ГГВББВА
- 35. Бас миының абцессі А.нейтрофильдың және
- 36. Бас миының туберкуломасыА. ТуберкуломаА
- 37. Вирусты менингитА. Периваскулярлы лимфоциттармен толған тамырларБ. Ми тінінің лимфолейкоцитарлы инфильтрациясыААБ
- 38. Бас миының абсцессіА. Абсцесс қуысыА
- 39. Саңырауқұлақты менингитА. Зақымдалу аймағы – «сабынды көпіршік» түріндегі ми тініА
- 40. Қатерлі гипертензия кезіндегі фибриноидты некрозА.Шумақша ілмектеріБ. Фибриноидты некрозБА
- 41. Скачать презентанцию
Бактериальді менингитА. Мидың жұмсақ қабаты Б.Торлы қабаты В.Менингеальді аралық қабынумен Г. Ми қыртысы АБВГ